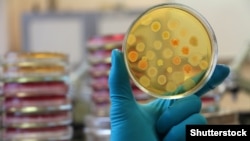

Дагестанские журналисты во главе с Мухтаром Амировым подозревают американскую лабораторию, расположенную в Грузии, в применении биологического оружия в Дагестане и Чечне. Только дагестанские ученые ничего об этом не слышали. А грузинские эксперты отказываются всерьез это обсуждать.
Как пояснил в беседе с "Кавказ.Реалии" Мухтар Амиров, речь идет о военно-биологическом центре, названном в честь создателя развития биолабораторий по миру Ричарда Лугара. Находится он в 17 километрах от военной базы Вазиани в пригороде Тбилиси.
По мнению собеседника, начиная с 2015 года одновременно с Тбилиси, в Дагестане появились кусающие мухи, которые живут в закрытых помещениях целый год и выносят низкую температуру. "Их укусы вызывают сыпь", - утверждает Амиров.
Журналист также приписывает этой лаборатории и вспышку нодулярного дерматита, который впервые зарегистрирован в республике в том же 2015 году.
Недавно на государственном телевизионном канале в Дагестане был показан сюжет на эту тему.
"Некоторые недальновидные дагестанские животноводы скрывали факты падежа скота, утилизация трупов животных происходила без соблюдения ветеринарно-санитарных правил и без уведомления контрольных органов, - пишет Мухтар Амиров в статье под названием "Дагестан под угрозой биологического оружия" в "Аргументах и Фактах".
Есть еще много фактов, свидетельствующих о распространении американской лабораторией искусственных вирусов, как в Грузии, так и по соседству, в том числе и в Дагестане, утверждает Амиров.
На днях он создал петицию, адресованную Владимиру Путину, с тем, чтобы инициировать "проведение расследования деятельности лаборатории Лугара в связи с угрозой биологической безопасности граждан России", а также введения санкций против физических и юридических лиц, имеющих отношение к данной лаборатории.
В то же время Амиров ищет контактов с научным сообществом, которое откликнулось бы на эту проблему.
Дагестанские ученые пока никак не отреагировали на это, судя по нашему разговору с Амировым. К тому же, врио председателя Дагестанского научного центра РАН Акай Муртазаев в телефонной беседе с "Кавказ.Реалии" ответил, что там ничего не слышали о биооружии в Грузии.
"Многие, с кем мы контактируем, не говорят об этом, - поясняет Амиров. – Да, мы понимаем, что такую версию надо подтверждать лабораторно. Но это всего лишь наша гипотеза, ее надо либо опровергнуть, либо подтвердить".
По его словам, они опираются на открытые данные, которые отправляли в профильные заведения республики.
Коллеги и знакомые Мухтара Амирова недоумевают: зачем ему это, нет ли в нем политического подтекста, "почему ты пугаешь людей перед выборами"?
Журналист отрицает личную заинтересованность в раздувании страхов по поводу биолаборатории в Грузии.
"Я не имею какой-нибудь фермы или крупно-рогатого скота, чтобы лоббировать чисто экономические интересы. Это касается лично меня и каждого из нас. Когда мы все начнем болеть, не будем понимать, откуда эта зараза? А, может быть, кто-то сидит в Махачкале и распространяет эту болезнь?" - предупреждает Амиров.
"В такие фейки давно уже никто не верит"
Грузинский эксперт, пожелавший не называть себя, в разговоре с "Кавказ.Реалии" отметил, что это очередная дезинформация, которую целенаправленно распространяет российская сторона: "И как обычно никакого обоснования, никаких фактов, подтверждающих эту глупость. Даже помню, года три назад, распространяли примерно такой же фейк, будто Грузия умышленно распространила свиной грипп на территории Северного Кавказа через Дагестан, что в итоге вызвало массовую гибель свиней в этом регионе России. А сейчас этот грипп перенесли на мух и крупный рогатый скот". Эксперт отмечает, что, желая в очередной раз обвинить Грузию, они сами же и оказываются в смешной ситуации. "В такие фейки давно уже никто не верит", - говорит он.
На просьбу "Кавказ.Реалии" высказать свое мнение по данному сюжету на дагестанском госканале, известный грузинский эксперт по вопросам безопасности Торнике Шарашенидзе отметил, что ему "пришлось изрядно напрячься, чтобы комментировать серьезно эту глупость".
"Могу сказать, что с таким же успехом Грузия может обвинить Россию, что она запускает на нашу территорию бешенных кошек. А всерьёз: во-первых, понятно, что обвинять США во всех грехах - это апробированный метод в российских СМИ, но всё имеет свой предел. Во-вторых, Грузия - это независимое государство, само принимающее решения в Тбилиси, а не в Вашингтоне. В-третьих, в Грузии очень сильные неправительственные организации, которые не пропустили бы такой ужас без внимания", - отметил Шарашенидзе.
Национальный центр по контролю заболеваний и общественного здоровья Грузии ("биолаборатория Лугара") – это закрытый объект. Как пишут многие грузинские СМИ, миссия лаборатории - выявление биологических угроз и их предупреждение. Лаборатория была открыта в рамках американской правительственной "Программы совместного уменьшения угрозы" и получила имя одного из авторов проекта - американского сенатора Ричарда Лугара. После смены власти в Грузии в 2012 году, Центр общественного здравоохранения имени Ричарда Лугара был закрыт, а все его имущество было передано Национальному центру контроля заболеваний и общественного здоровья Грузии.